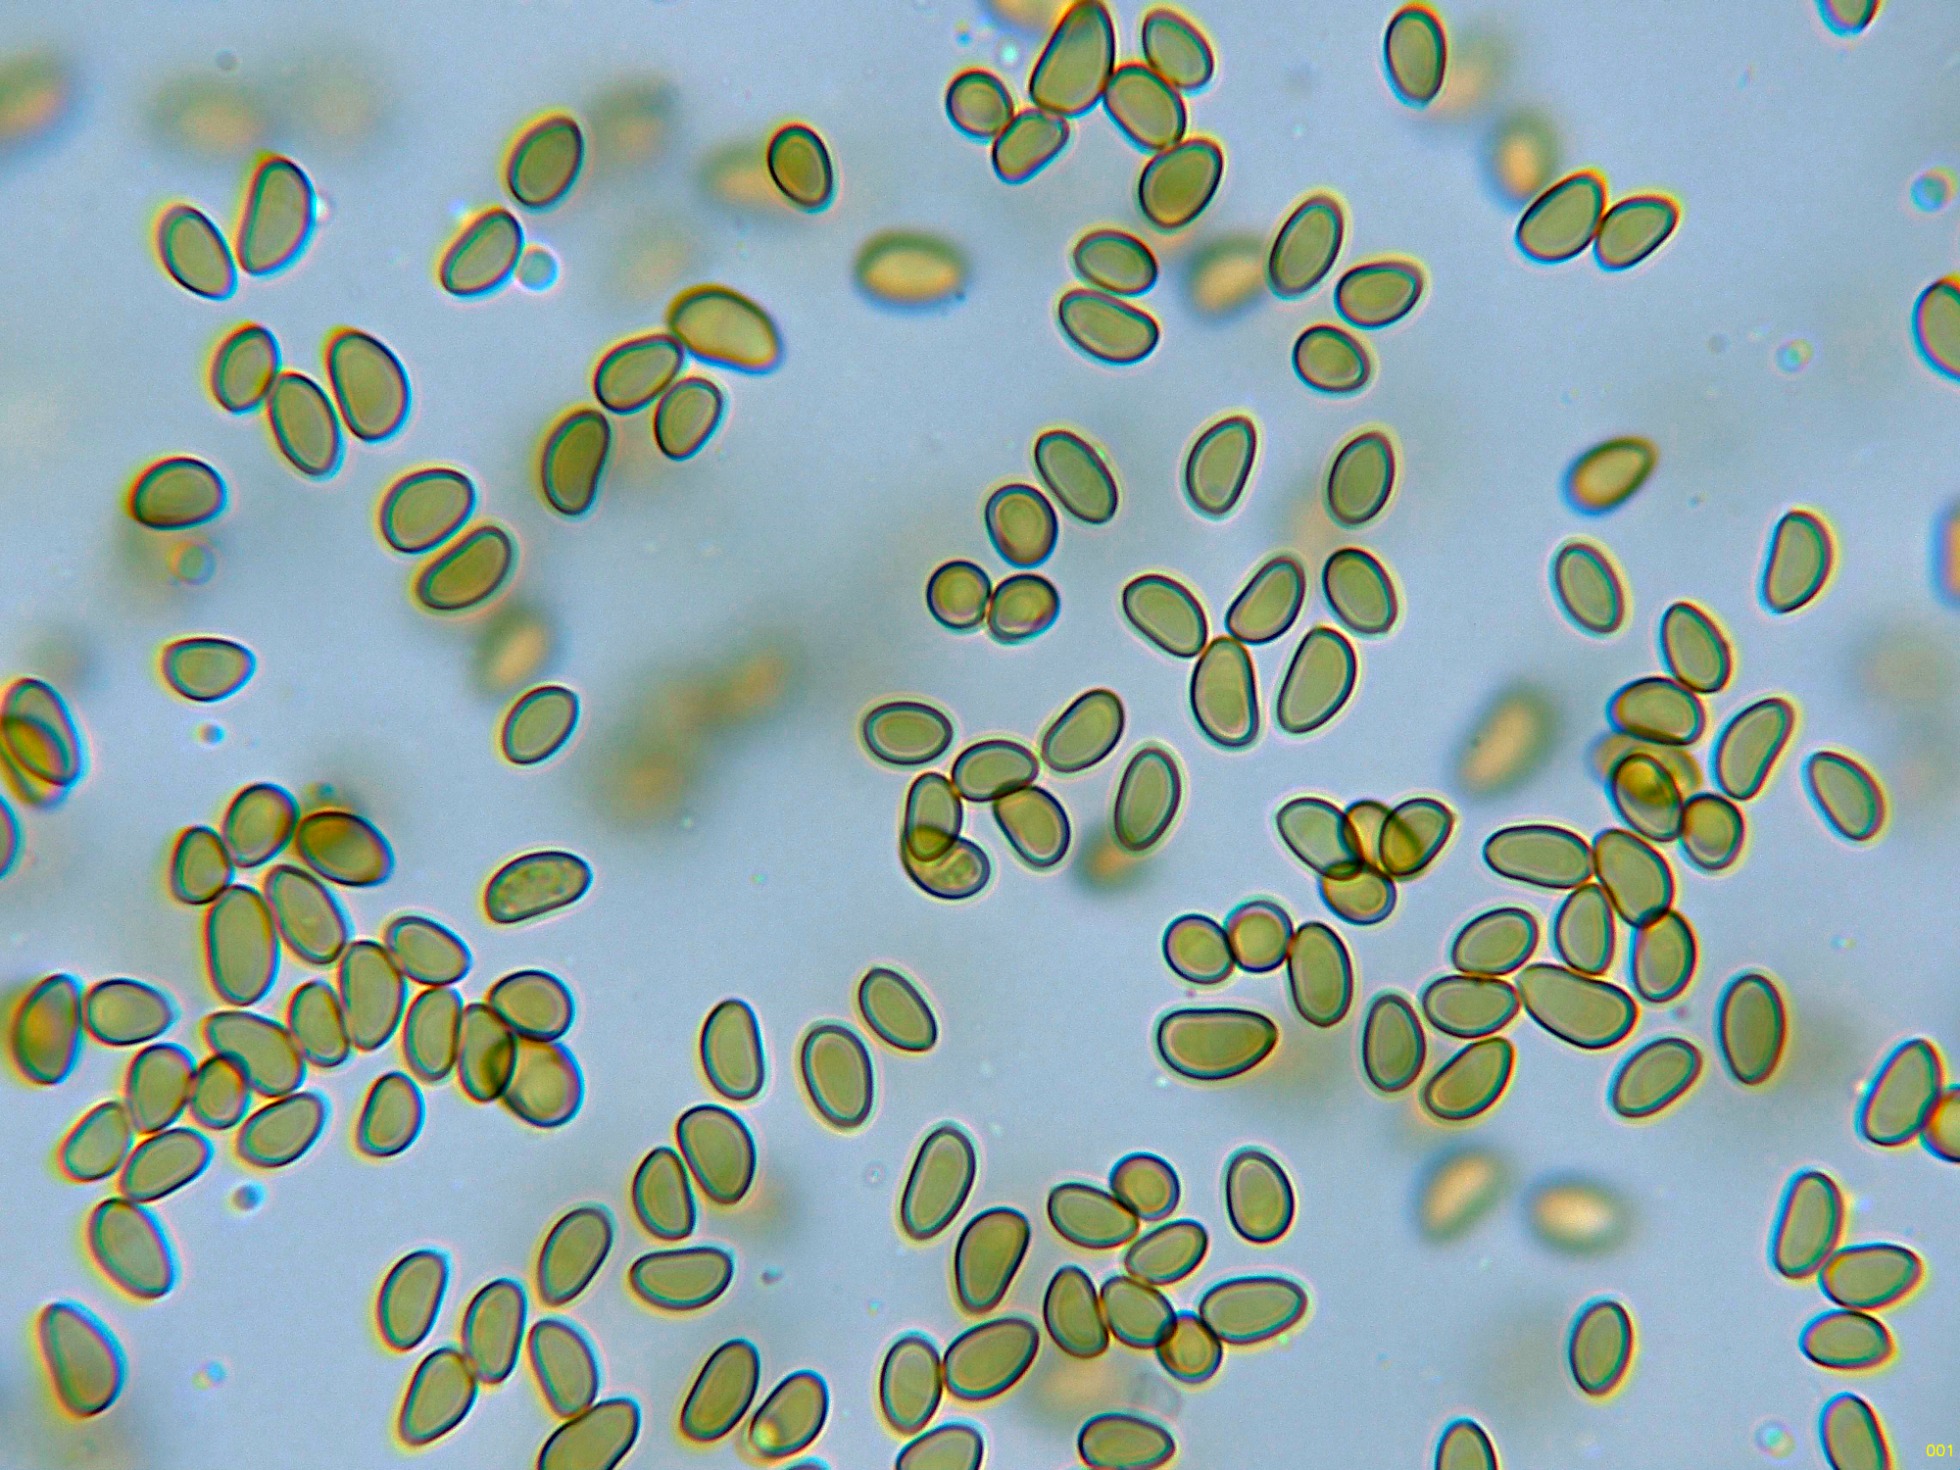
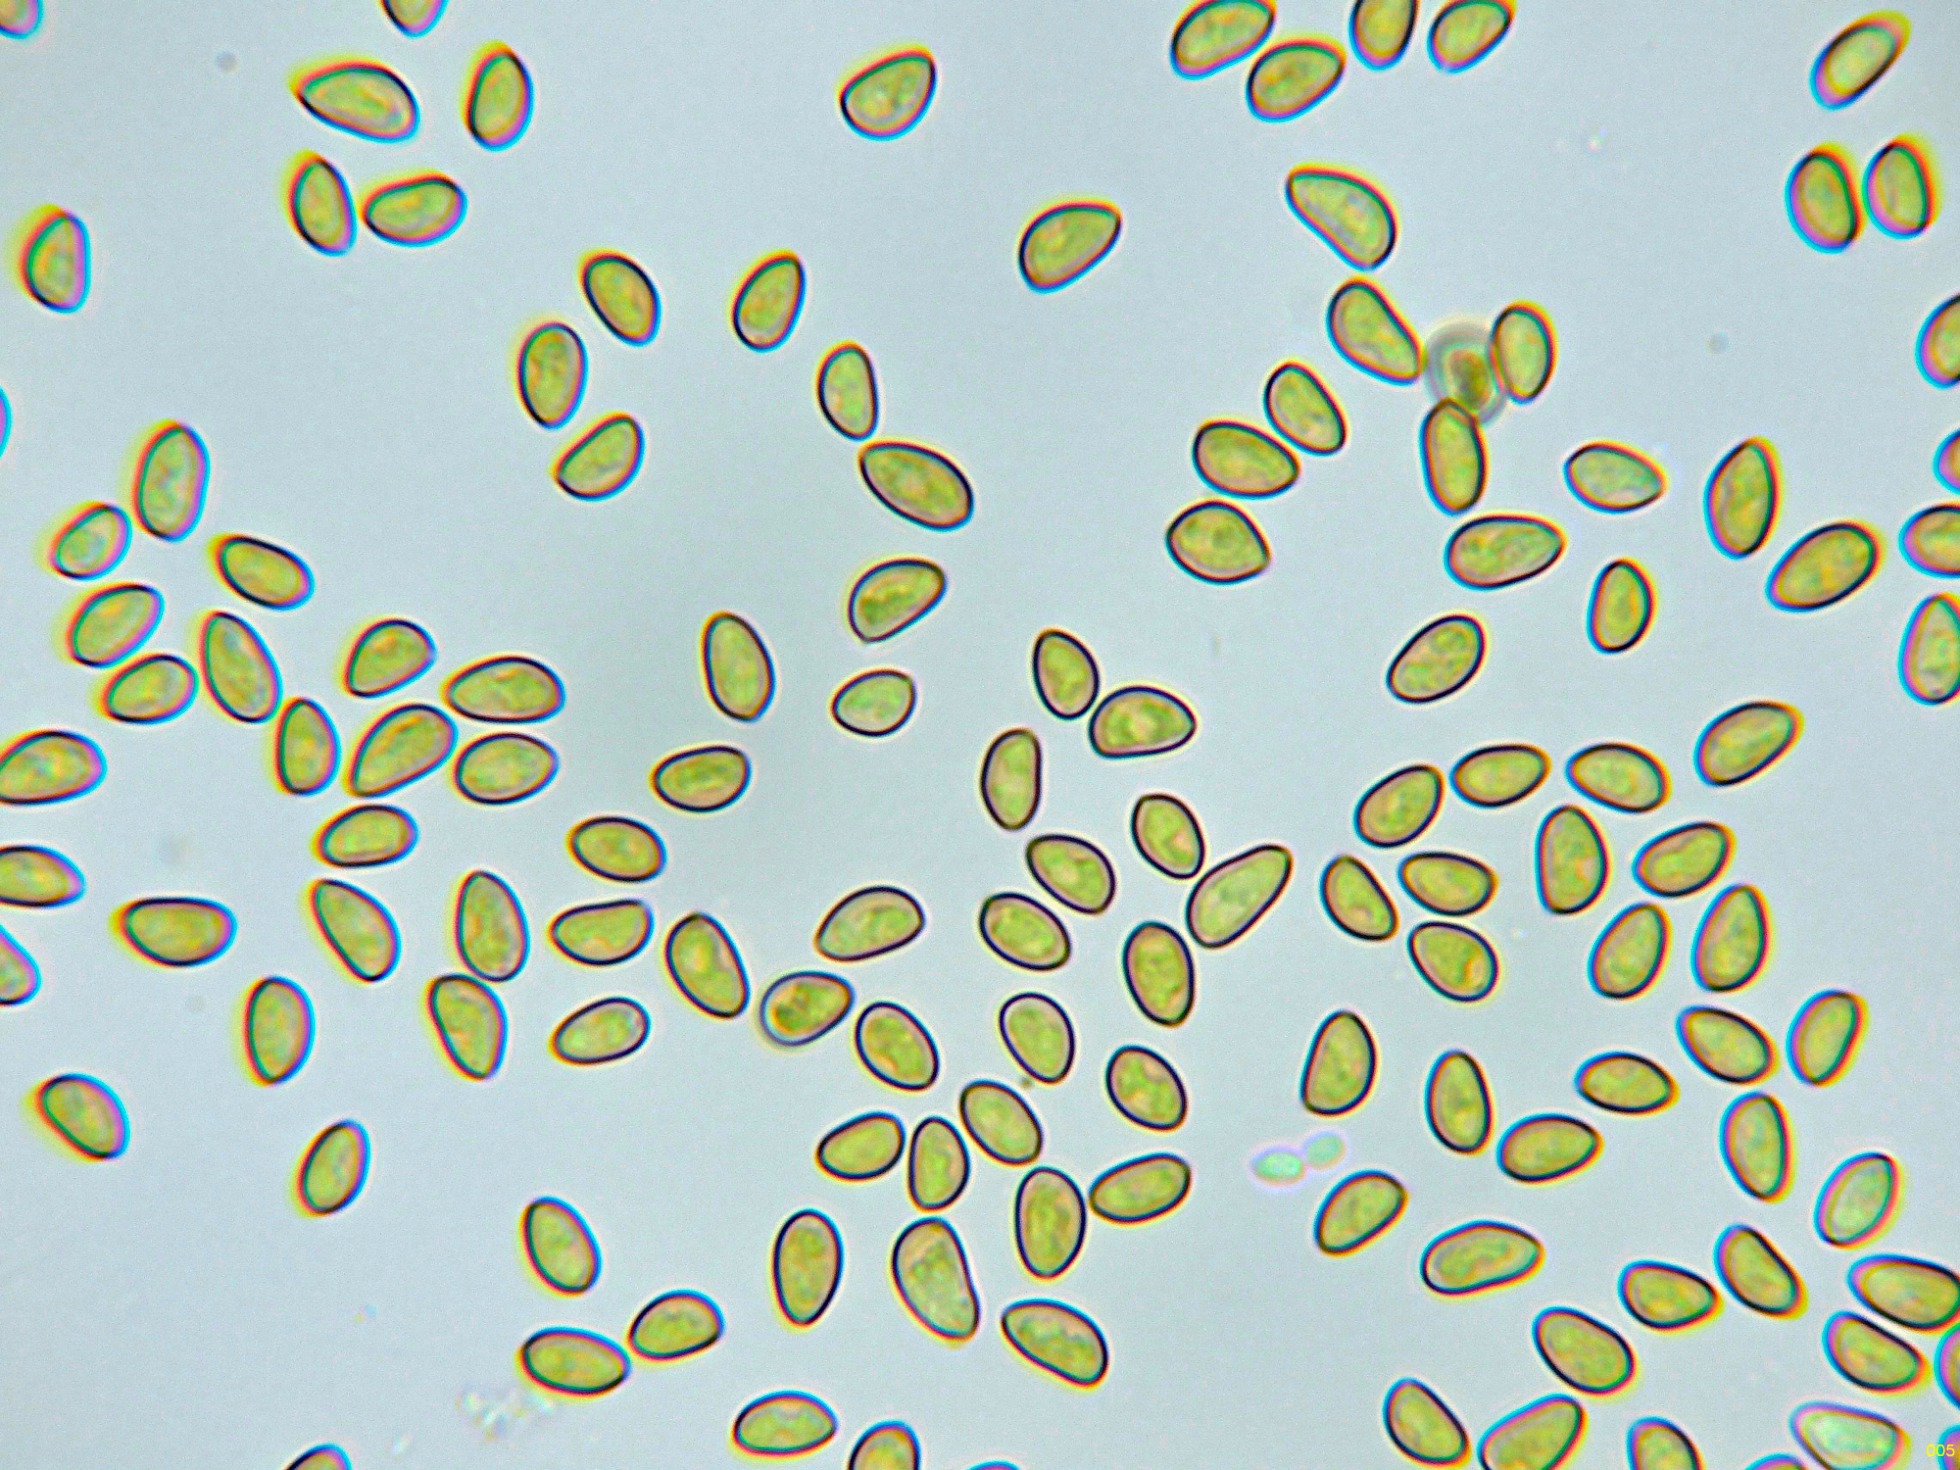

- Foro
- Foros sobre Micología de fungipedia
- Microscopía
- De nuevo por Urbasa: (1) Flammulaster limulatus (Fr.) Watling
 De nuevo por Urbasa: (1) Flammulaster limulatus (Fr.) Watling
De nuevo por Urbasa: (1) Flammulaster limulatus (Fr.) Watling
- Josep Torres
-
 Autor del tema
Autor del tema
- Ausente
- Moderador
-

Menos
Más
- Mensajes: 8746
- Gracias recibidas: 8379
2 años 6 meses antes #109311
por Josep Torres
Hola a tod@s.
El pasado sábado 7 de octubre, tuve el inmenso placer de poder compartir una salida con los amigos de Miranda de Ebro.
Agradecer a Luís Abadía Díez, Fernando Sainz y Miguel Ángel Unceta, su ayuda y todas las atenciones recibidas.
Como primer "cromo nuevo" he escogido este Flammulaster, un género bastante fotogénico, hasta la fecha solo había estudiado el Flammulaster carpophilus y el Flammulaster granulosus, ahora le ha tocado el turno al:
Flammulaster limulatus (Fr.) Watling
Detalle del pie lanoso y láminas.
Escamas del sombrero a 40 aumentos.
Suprapellis con hifas provistas de pigmento intracelular y fibuladas.
Las hifas de las escamas, algo más estrechas y fuertemente pigmentadas.
Hifas terminales de la estipitipellis en manojos.
Estas hifas a modo de caulocistidios a 400 aumentos.
Queilocistidios hialinos y muy abundantes que dejan estéril la arista laminar.
Los basidios mayoritariamente tetraspóricos.
También de manera aislada algunos basidios bispóricos, estos serían los responsables de alguna espora anormalmente grande.
Las esporas en Reactivo de Melzer, con reacción moderadamente dextrinoide.
Las esporas en agua.
Estas esporas obtenidas por esporulación natural y en agua con unas medidas de:
(6.3) 6.7 - 8.3 (9) × (4.1) 4.2 - 4.9 (5.7) µm
Q = (1.3) 1.5 - 1.7 (2) ; N = 40
Me = 7.4 × 4.7 µm ; Qe = 1.6
Saludos a tod@s.
El pasado sábado 7 de octubre, tuve el inmenso placer de poder compartir una salida con los amigos de Miranda de Ebro.
Agradecer a Luís Abadía Díez, Fernando Sainz y Miguel Ángel Unceta, su ayuda y todas las atenciones recibidas.
Como primer "cromo nuevo" he escogido este Flammulaster, un género bastante fotogénico, hasta la fecha solo había estudiado el Flammulaster carpophilus y el Flammulaster granulosus, ahora le ha tocado el turno al:
Flammulaster limulatus (Fr.) Watling
Detalle del pie lanoso y láminas.
Escamas del sombrero a 40 aumentos.
Suprapellis con hifas provistas de pigmento intracelular y fibuladas.
Las hifas de las escamas, algo más estrechas y fuertemente pigmentadas.
Hifas terminales de la estipitipellis en manojos.
Estas hifas a modo de caulocistidios a 400 aumentos.
Queilocistidios hialinos y muy abundantes que dejan estéril la arista laminar.
Los basidios mayoritariamente tetraspóricos.
También de manera aislada algunos basidios bispóricos, estos serían los responsables de alguna espora anormalmente grande.
Las esporas en Reactivo de Melzer, con reacción moderadamente dextrinoide.
Las esporas en agua.
Estas esporas obtenidas por esporulación natural y en agua con unas medidas de:
(6.3) 6.7 - 8.3 (9) × (4.1) 4.2 - 4.9 (5.7) µm
Q = (1.3) 1.5 - 1.7 (2) ; N = 40
Me = 7.4 × 4.7 µm ; Qe = 1.6
Saludos a tod@s.
Adjuntos:
El siguiente usuario dijo gracias: Juan Andrés Román, Juan
Por favor, Identificarse para unirse a la conversación.
- Juan Andrés Román
-

- Fuera de línea
- Spammer
-

Menos
Más
- Mensajes: 2558
- Gracias recibidas: 2756
2 años 6 meses antes #109320
por Juan Andrés Román
Respuesta de Juan Andrés Román sobre el tema De nuevo por Urbasa: (1) Flammulaster limulatus (Fr.) Watling
El siguiente usuario dijo gracias: Josep Torres, Juan
Por favor, Identificarse para unirse a la conversación.
- Josep Torres
-
 Autor del tema
Autor del tema
- Ausente
- Moderador
-

Menos
Más
- Mensajes: 8746
- Gracias recibidas: 8379
2 años 6 meses antes #109327
por Josep Torres
Respuesta de Josep Torres sobre el tema De nuevo por Urbasa: (1) Flammulaster limulatus (Fr.) Watling
El siguiente usuario dijo gracias: Juan Andrés Román, Juan
Por favor, Identificarse para unirse a la conversación.
- Javi Calvo
-

- Fuera de línea
- Spammer
-

Menos
Más
- Mensajes: 7009
- Gracias recibidas: 2955
2 años 6 meses antes #109338
por Javi Calvo
Respuesta de Javi Calvo sobre el tema De nuevo por Urbasa: (1) Flammulaster limulatus (Fr.) Watling
El siguiente usuario dijo gracias: Juan Andrés Román, Josep Torres
Por favor, Identificarse para unirse a la conversación.
- Josep Torres
-
 Autor del tema
Autor del tema
- Ausente
- Moderador
-

Menos
Más
- Mensajes: 8746
- Gracias recibidas: 8379
2 años 6 meses antes #109341
por Josep Torres
Respuesta de Josep Torres sobre el tema De nuevo por Urbasa: (1) Flammulaster limulatus (Fr.) Watling
El siguiente usuario dijo gracias: Juan Andrés Román, Juan
Por favor, Identificarse para unirse a la conversación.
- Juan
-

- Fuera de línea
- Moderador
-

Menos
Más
- Mensajes: 553
- Gracias recibidas: 608
2 años 5 meses antes #109441
por Juan
Respuesta de Juan sobre el tema De nuevo por Urbasa: (1) Flammulaster limulatus (Fr.) Watling
Increíble!! muy fotogénico dicho ejemplar! las capturas de las escamas del sombrero a 40 aumentos... sin palabras 
El siguiente usuario dijo gracias: Josep Torres
Por favor, Identificarse para unirse a la conversación.
- Foro
- Foros sobre Micología de fungipedia
- Microscopía
- De nuevo por Urbasa: (1) Flammulaster limulatus (Fr.) Watling
Tiempo de carga de la página: 0.216 segundos

Foro de micología